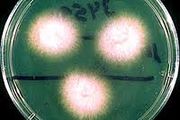

Lista de archivos
Esta página especial muestra todos los archivos subidos.
| Fecha | Nombre | Miniatura | Tamaño | Descripción | Versiones |
|---|---|---|---|---|---|
| 11:15 8 mar 2020 | Prodigiosa.jpg (archivo) |  |
393 KB | 1 | |
| 11:09 8 mar 2020 | Alimento-4.jpg (archivo) |  |
44 KB | 1 | |
| 18:15 13 dic 2019 | Shabat.jpg (archivo) |  |
6 KB | 1 | |
| 15:26 17 oct 2019 | Índice.258jpg.jpg (archivo) |  |
11 KB | 1 | |
| 15:12 17 oct 2019 | Índice423.jpg (archivo) |  |
20 KB | 1 | |
| 11:39 6 jun 2016 | Vestimenta-en-la-antigedad-7-728.jpg (archivo) |  |
87 KB | 1 | |
| 15:54 28 may 2016 | Rn.jpg (archivo) |  |
5 KB | 1 | |
| 19:36 15 sep 2015 | Dt.common.streams.StreamServer.cls.jpeg (archivo) |  |
93 KB | 1 | |
| 15:35 27 abr 2015 | Lucha-Reyes1.jpg (archivo) |  |
33 KB | 1 | |
| 09:54 26 mar 2015 | Antonio Aguilar.jpeg (archivo) |  |
4 KB | 1 | |
| 17:37 10 ene 2015 | Shha1.gif (archivo) |  |
14 KB | 1 | |
| 17:04 6 dic 2013 | Nitazoxamida.jpeg (archivo) |  |
4 KB | 1 | |
| 16:22 6 dic 2013 | Jejenbufalo.jpg (archivo) |  |
2 KB | 1 | |
| 16:46 5 dic 2013 | IMG 0012.JPG (archivo) |  |
11 KB | 1 | |
| 11:59 5 dic 2013 | Enfermeddes hemorragipars.JPG (archivo) |  |
10 KB | 1 | |
| 11:06 5 dic 2013 | MANAYUPA.jpeg (archivo) |  |
4 KB | 1 | |
| 17:12 4 dic 2013 | Fusiarium.jpeg (archivo) | |
5 KB | 1 | |
| 15:48 4 dic 2013 | Paronimas.jpg (archivo) |  |
89 KB | 1 | |
| 12:42 4 dic 2013 | Enroflox.jpeg (archivo) |  |
7 KB | 1 | |
| 10:16 4 dic 2013 | Insomnio Infantil.jpeg (archivo) |  |
6 KB | 1 | |
| 09:34 4 dic 2013 | Rimadyl.jpg (archivo) |  |
22 KB | 1 | |
| 16:40 29 nov 2013 | Hipronimia2.jpg (archivo) |  |
7 KB | 1 | |
| 10:13 21 oct 2013 | Instrumento Primitivo Honda.jpeg (archivo) |  |
5 KB | 1 | |
| 11:22 17 oct 2013 | Deformaciones dento faciales.JPG (archivo) |  |
8 KB | 1 | |
| 12:10 16 oct 2013 | Paradontopatía.JPG (archivo) |  |
7 KB | 1 | |
| 12:13 11 oct 2013 | Neotrofin.JPG (archivo) |  |
31 KB | 1 | |
| 16:52 7 jun 2013 | Encefalopatia 1.jpeg (archivo) |  |
10 KB | 1 | |
| 16:08 6 jun 2013 | Nefropatía2.jpeg (archivo) |  |
5 KB | 1 | |
| 16:05 6 jun 2013 | Fusi5.jpeg (archivo) |  |
13 KB | 1 | |
| 15:56 6 jun 2013 | Fusil4.jpeg (archivo) |  |
6 KB | 1 | |
| 15:52 6 jun 2013 | Fusil de asalto2.jpeg (archivo) |  |
6 KB | 1 | |
| 15:49 6 jun 2013 | Radio por internet 1.jpeg (archivo) |  |
8 KB | 1 | |
| 15:45 6 jun 2013 | Ametra 1.jpeg (archivo) |  |
6 KB | 1 | |
| 15:41 6 jun 2013 | Fusi3.jpeg (archivo) |  |
6 KB | 1 | |
| 15:36 6 jun 2013 | Fusi2.jpeg (archivo) |  |
7 KB | 1 | |
| 15:29 6 jun 2013 | Mammi.jpeg (archivo) |  |
9 KB | 1 | |
| 15:10 6 jun 2013 | Yin.jpeg (archivo) |  |
6 KB | 1 | |
| 14:37 6 jun 2013 | Secuencia.jpeg (archivo) |  |
10 KB | 1 | |
| 14:34 6 jun 2013 | Lo imp.jpeg (archivo) |  |
9 KB | 1 | |
| 17:50 5 jun 2013 | Linux1.jpeg (archivo) |  |
11 KB | 1 | |
| 17:47 5 jun 2013 | Separación v.jpeg (archivo) |  |
9 KB | 1 | |
| 17:27 5 jun 2013 | Mejo.jpeg (archivo) |  |
6 KB | 1 | |
| 17:17 5 jun 2013 | Ministerio1.jpeg (archivo) |  |
10 KB | 1 | |
| 16:52 5 jun 2013 | Distoxia1.jpeg (archivo) |  |
5 KB | 1 | |
| 16:47 5 jun 2013 | Miembros1.jpeg (archivo) |  |
12 KB | 1 | |
| 16:36 5 jun 2013 | Edif.jpeg (archivo) |  |
9 KB | 1 | |
| 16:23 5 jun 2013 | Mesca.jpeg (archivo) |  |
11 KB | 1 | |
| 16:14 5 jun 2013 | Naftaleno1.jpeg (archivo) |  |
8 KB | 1 | |
| 16:08 5 jun 2013 | Manni.jpeg (archivo) |  |
10 KB | 1 | |
| 15:18 5 jun 2013 | Holdenm.jpeg (archivo) |  |
12 KB | 1 |